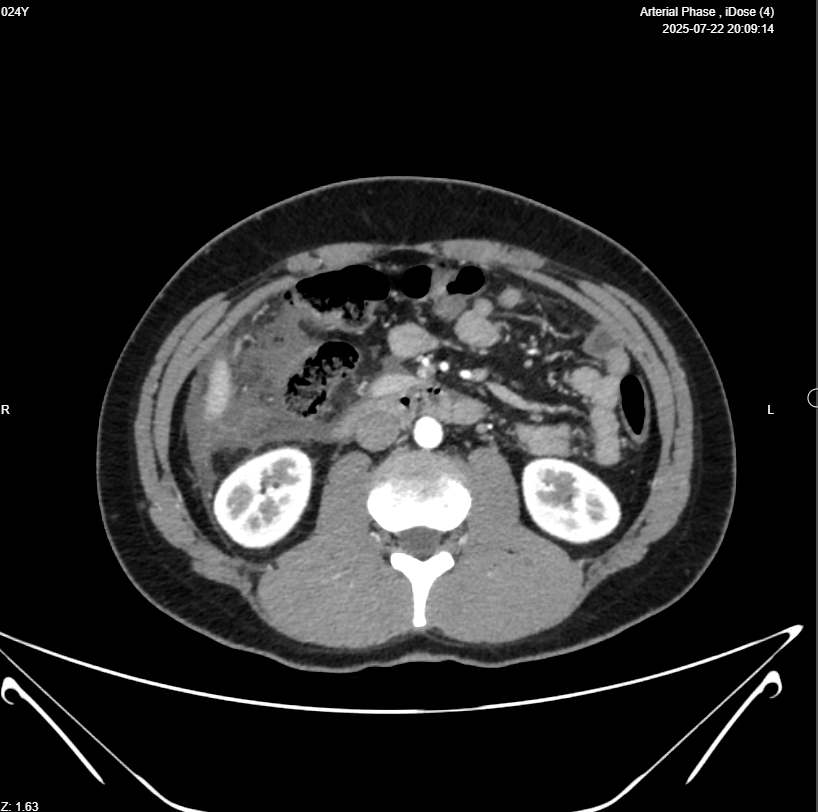
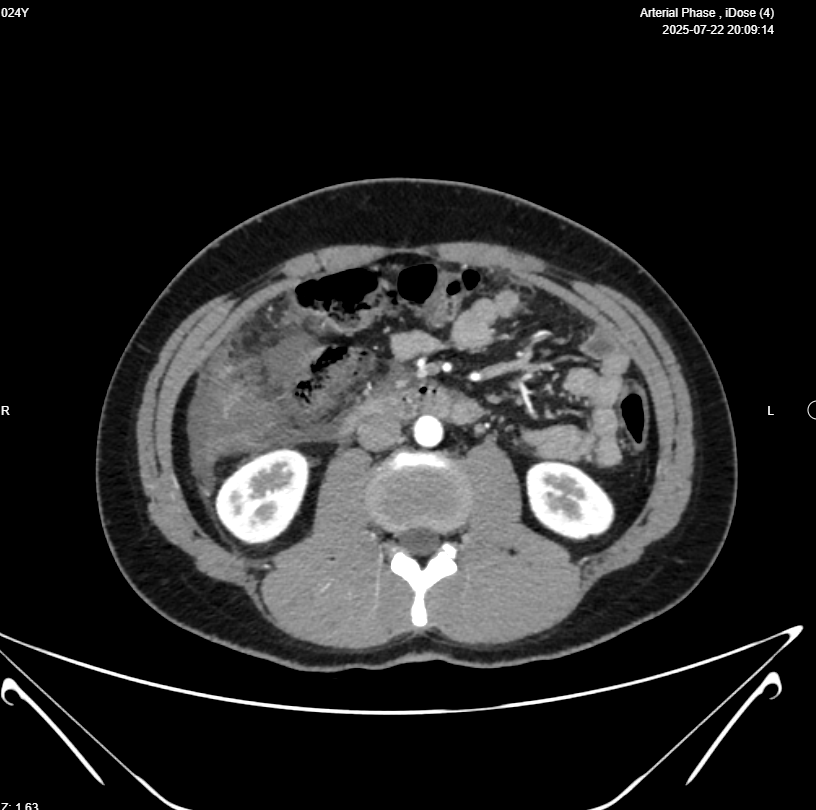

Right iliac fossa presence of Blind loop small bowel mass 39x16mm (Appendicitis ?) , associated with heterogenous mass 112x53mm , in the right sided sub-hepatic region, also associated with dilated bowel loop 26mm (ilieus?) & free intrabdominal fluid >100cc , picture mostly of ruptured viscus appendix ? with its sequel ?? , please for further study



Abdominal CT With IV Contrast
Clinical data: Appendicular mass.
- Evidence of 9 X 8 X 4cm Rt abdominal collection from Rt subhepatic region to RIF, contains fluid and gas, suggestive of an abscess, mostly from perforated appendix.
- Appendix shows diffuse wall thickening, diameter 11mm, with 2.5 X 2.5cm heterogeneously enhanced part in its tip which is in lower part of above mentioned collection, contains few calcifications, which raise suspicion of mucinous tumor.
- Marked inflammation in Rt subhepatic, paracolic gutter, which is surrounding cecum and ascending colon.
- Mild ascites.
- Several mesenteric LNs, mostly inflammatory.